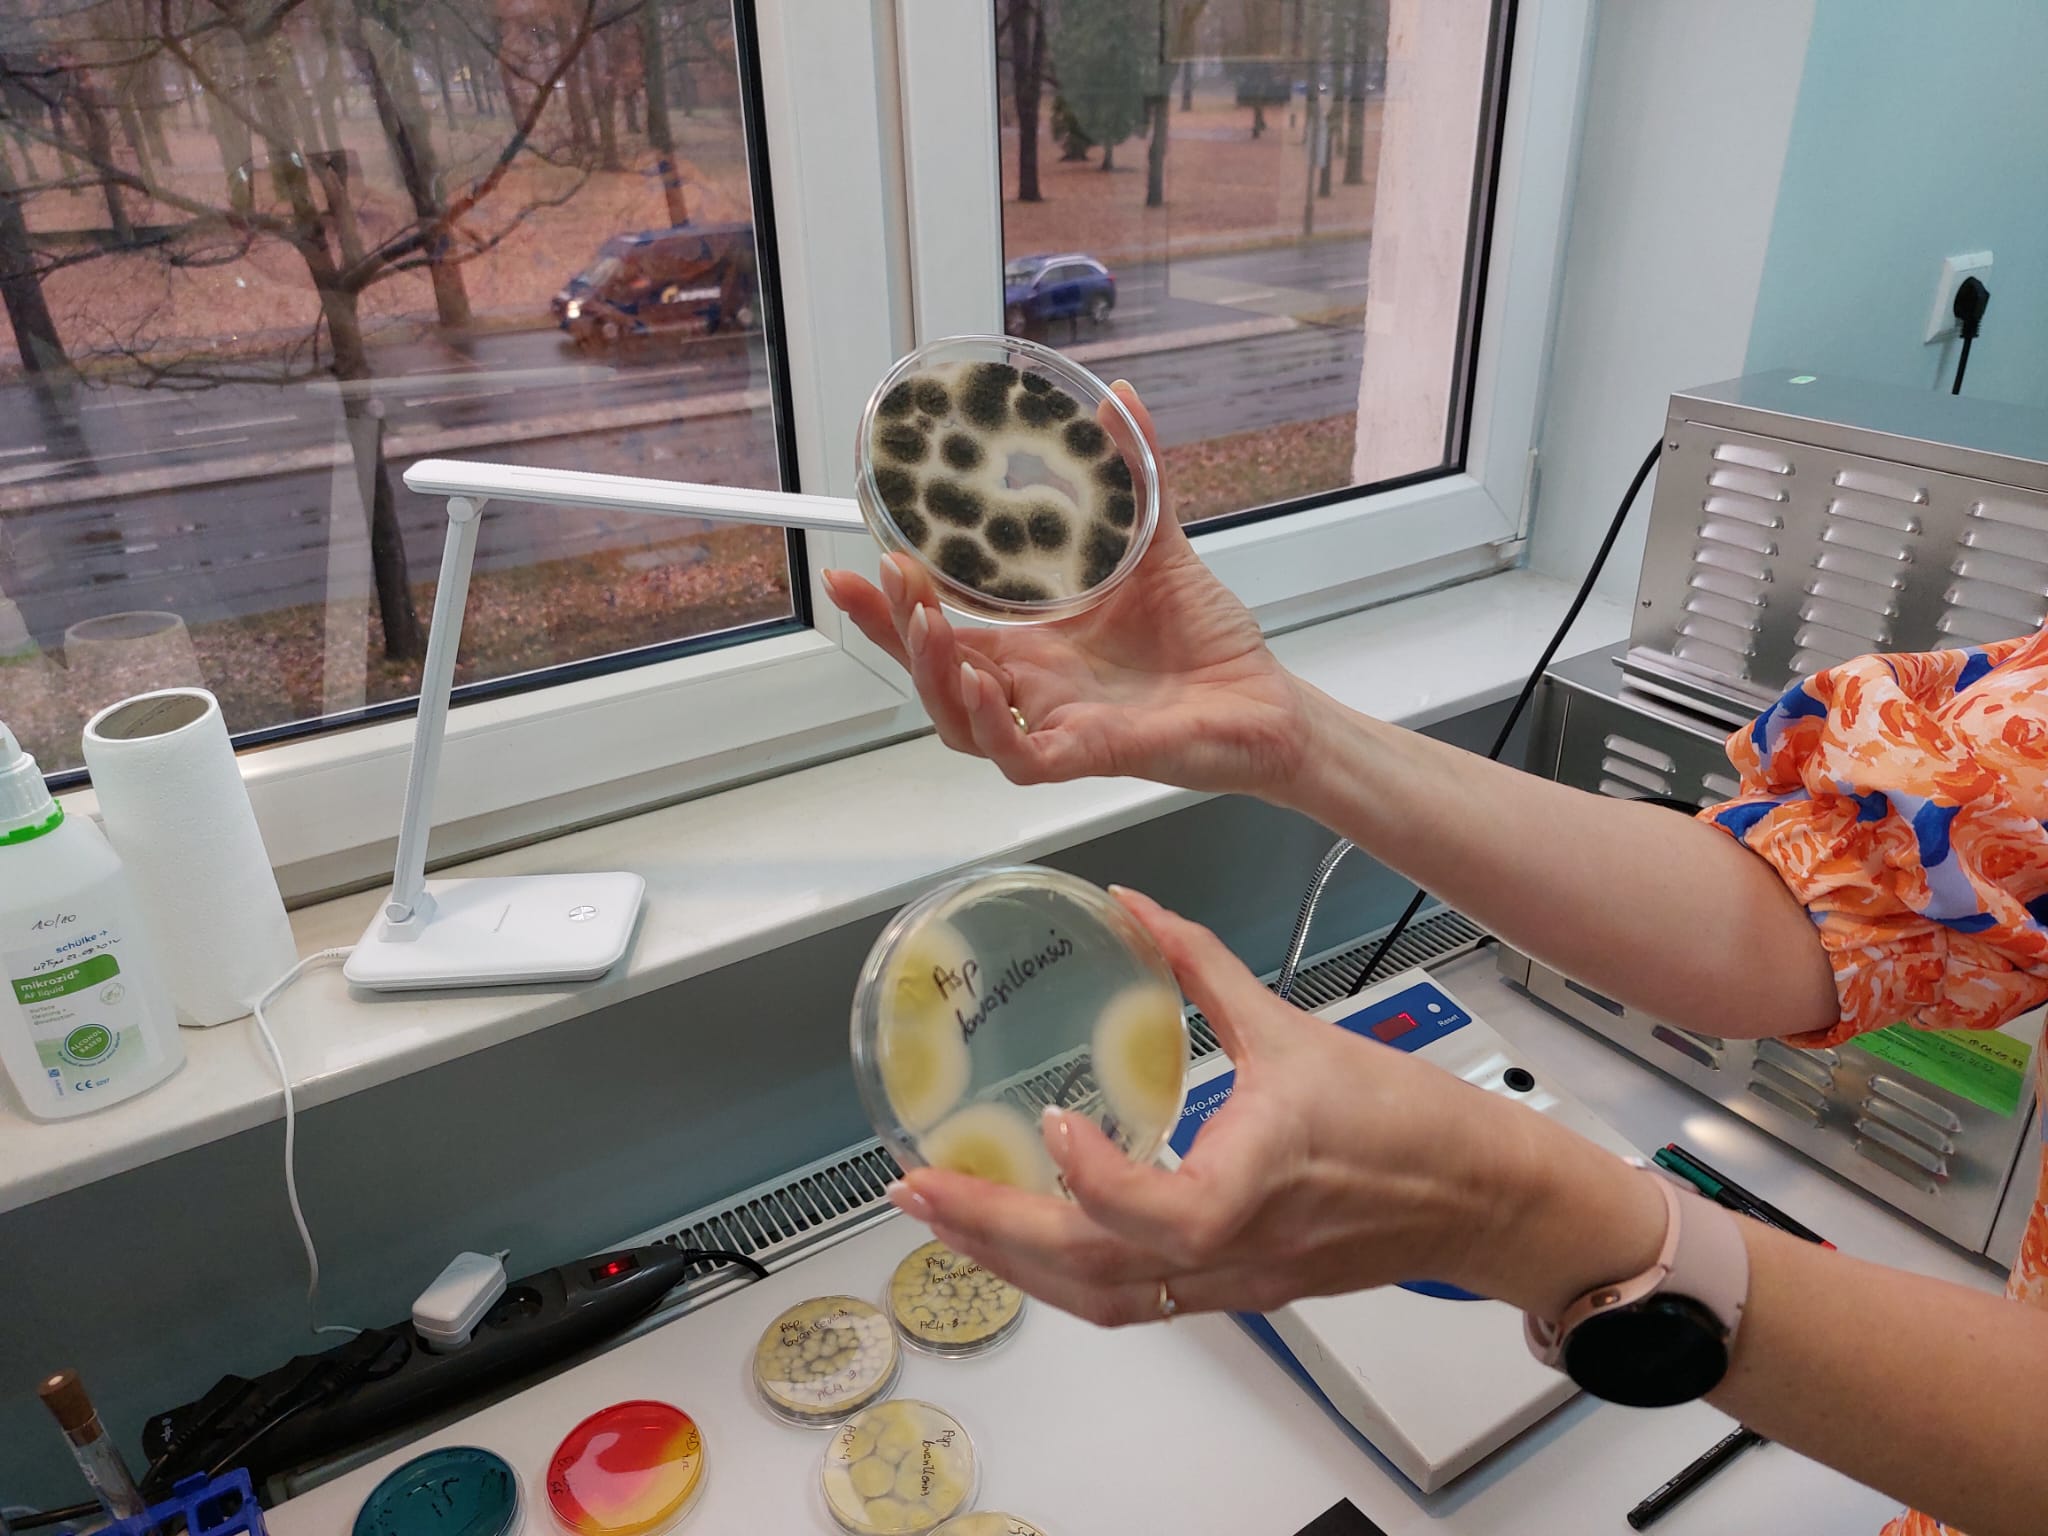

Ogólnopolska narada IJHARS. Podsumowanie roku 2024 oraz wyzwania na 2025 r.
23.12.2024
Podsumowanie zadań wykonanych w ciągu mijającego roku, analiza inicjatyw pracowniczych zrealizowanych metodą projektową, omówienie celów strategicznych określonych przez Najwyższe Kierownictwo IJHARS na rok 2025, wreszcie rozmowy na temat szczegółów nowelizacji ustawy o jakości handlowej artykułów rolno-spożywczych w głównej mierze wypełniły trzy intensywne dni rozmów i prezentacji. Narada IJHARS była także okazją do spotkań z Jarosławem Maciejewskim, wicewojewodą wielkopolskim oraz Grzegorzem Sobczyńskim, Zastępcą Dyrektora Departamentu Rolnictwa Ekologicznego i Jakości Żywności w MRiRW.

W spotkaniu zorganizowanym w dniach 4-6 grudnia 2024 r. w Poznaniu uczestniczyło najwyższe Kierownictwo Inspekcji z Przemysławem Rzodkiewiczem, Głównym Inspektorem na czele, dyrektorzy biur i laboratoriów GIJHARS oraz wojewódzcy inspektorzy IJHARS z 16 województw. Gościem specjalnym narady był wicewojewoda wielkopolski, Jarosław Maciejewski. W naradzie jako przedstawiciel Ministerstwa Rolnictwa i Rozwoju Wsi uczestniczył Pan Grzegorz Sobczyński, zastępca dyrektora Departamentu Rolnictwa Ekologicznego i Jakości. Spotkanie było więc okazją do omówienia zadań realizowanych przez IJHARS w perspektywie aktywności w regionie i wyzwań, z którymi mierzą się wojewódzkie inspektoraty.
W pierwszym dniu omówiono wyzwania oraz kluczowe propozycje działań mających na celu doskonalenie komunikacji w IJHARS w kolejnych latach. Tomasz Białas, Dyrektor Biura Strategii i Kontroli Wewnętrznej GIJHARS omówił propozycje celów długoterminowych na lata 2025 – 2027.
Drugi dzień narady rozpoczęły swoją prezentacją Dorota Bocheńska, Dyrektor Biura Orzecznictwa i Legislacji oraz Anna Wolska, Dyrektor Biura Kontroli Jakości Handlowej, które omówiły założenia procedowanej aktualnie nowelizacji ustawy o jakości handlowej artykułów rolno-spożywczych.
Opublikowany listopadzie 2024 r. raport NIK dotyczący służby cywilnej był dobrą okazją do zapoznania wszystkich kierujących urzędami IJHARS z wnioskami raportu i rekomendacjami. Dorota Sobczak, dyrektor Biura Kadr i Szkoleń GIJHARS przedstawiła procesy, które były przedmiotem obserwacji i kontroli Najwyższej Izby Kontroli oraz rekomendacje wynikające z przeprowadzonej kontroli.
W trakcie spotkania podsumowano roczne doświadczenia dotyczące oddolnych inicjatyw pracowników IJHARS zgłoszonych do realizacji w formule projektowej. Ewa Krzyżewska -Kuran, Dyrektor generalna GIJHARS, Justyna Markowska-Gastoł, Pełnomocnik Głównego Inspektora ds. zarządzania projektami IJHARS oraz kierownicy projektów przedstawili efekty zrealizowanych w 2024 r. projektów. - Jesteśmy Instytucją, która się zmienia. Nabraliśmy wiatru w żagle, zmierzamy w dobrym kierunku i utrzymujmy dalej ten kurs. – podsumowała tę część spotkania Agnieszka Sudoł, Zastępca Głównego Inspektora.
Przemysław Rzodkiewicz, Główny Inspektor przedstawił zebranym cele strategiczne na rok 2025 określone przez kierownictwo dla całej Inspekcji. Są to:
- Oszustwa żywnościowe i zafałszowania.
- Interesariusze IJHARS.
- Rozwój kompetencji i kwalifikacji.
- Rozwój Intranetu.
- Zarządzanie przez cele.
- Nie zapominając o tych, które realizowaliśmy w 2024 roku, pamiętajmy, że nowo określone cele są niejako kontynuacją poprzednich. – wskazał Główny Inspektor. – Ochrona przed oszustwami żywnościowymi i zafałszowaniami stanowi sens czynności kontrolnych podejmowanych przez nasz Urząd, który stoi na straży jakości handlowej żywności oferowanej konsumentom w Polsce. Nasza uwaga skierowana jest na potrzeby i oczekiwania zróżnicowanych grup interesariuszy, zarówno w otoczeniu zewnętrznym (konsumenci, producenci, rolnicy), jak i w wewnątrz Inspekcji (pracownicy i kandydaci na pracowników), stąd podejmowane będą aktywne działania kierowane do różnych odbiorców naszych działań. Kadra IJHARS to wysoko kwalifikowani eksperci, o wysoko ocenianych kompetencjach, wiedzy i doświadczeniu, ale współczesny świat wymusza stawianie sobie coraz wyższych wymagań tym samym wymaga nieustannego doskonalenia i uczenia się. W nowym roku stawiamy też na nowoczesny Intranet – to serce Instytucji, pozwalające sprawnie działać całemu krwioobiegowi komunikacji Urzędu – od procedur i przepisów wykonawczych, poprzez wskazówki i aktualne informacje dla dotychczasowych i nowo zatrudnianych pracowników. To ujednolicenie standardów działania. Wreszcie – zarządzanie przez cele – sprawdzona koncepcja realizacji celów poszczególnych biur i laboratoriów wyznaczanych co kwartał dla sprawnego monitorowania osiąganych efektów.
Narada w Poznaniu była także okazją do zapoznania się z przebiegiem procesu technologicznego wypiekania produktu regionalnego, jakim jest rogal świętomarciński. W 2008 r. nazwa rogal świętomarciński (ChOG) została wpisana do unijnego rejestru chronionych nazw pochodzenia i chronionych oznaczeń geograficznych. Rogal świętomarciński (ChOG) to nie tylko pyszne ciastko, ale również symbol Poznania, mający swoje korzenie w polskiej historii.
Trzeci dzień narady poświęcony był działalności Laboratoriów IJHARS. Omówiono techniki służące wykrywaniu zafałszowań żywności oraz metody badania gatunkowości surowców. Podczas wizyty studyjnej, uczestnicy spotkania mogli zobaczyć w praktyce codzienną pracę wykonywaną w laboratoriach.
Zdjęcia (14)
 Pokaż zdjęcie 2 z galerii.
Pokaż zdjęcie 2 z galerii.
 Pokaż zdjęcie 3 z galerii.
Pokaż zdjęcie 3 z galerii.
 Pokaż zdjęcie 4 z galerii.
Pokaż zdjęcie 4 z galerii.
 Pokaż zdjęcie 5 z galerii.
Pokaż zdjęcie 5 z galerii.
 Pokaż zdjęcie 6 z galerii.
Pokaż zdjęcie 6 z galerii.
 Pokaż zdjęcie 7 z galerii.
Pokaż zdjęcie 7 z galerii.
 Pokaż zdjęcie 8 z galerii.
Pokaż zdjęcie 8 z galerii.
 Pokaż zdjęcie 9 z galerii.
Pokaż zdjęcie 9 z galerii.
 Pokaż zdjęcie 10 z galerii.
Pokaż zdjęcie 10 z galerii.
 Pokaż zdjęcie 11 z galerii.
Pokaż zdjęcie 11 z galerii.
 Pokaż zdjęcie 12 z galerii.
Pokaż zdjęcie 12 z galerii.
 Pokaż zdjęcie 13 z galerii.
Pokaż zdjęcie 13 z galerii.
Pokaż zdjęcie 14 z galerii.
Pokaż zdjęcie 14 z galerii.
